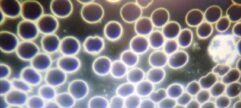

S’abonner
Connexion
0 Commentaires
Le plus récent